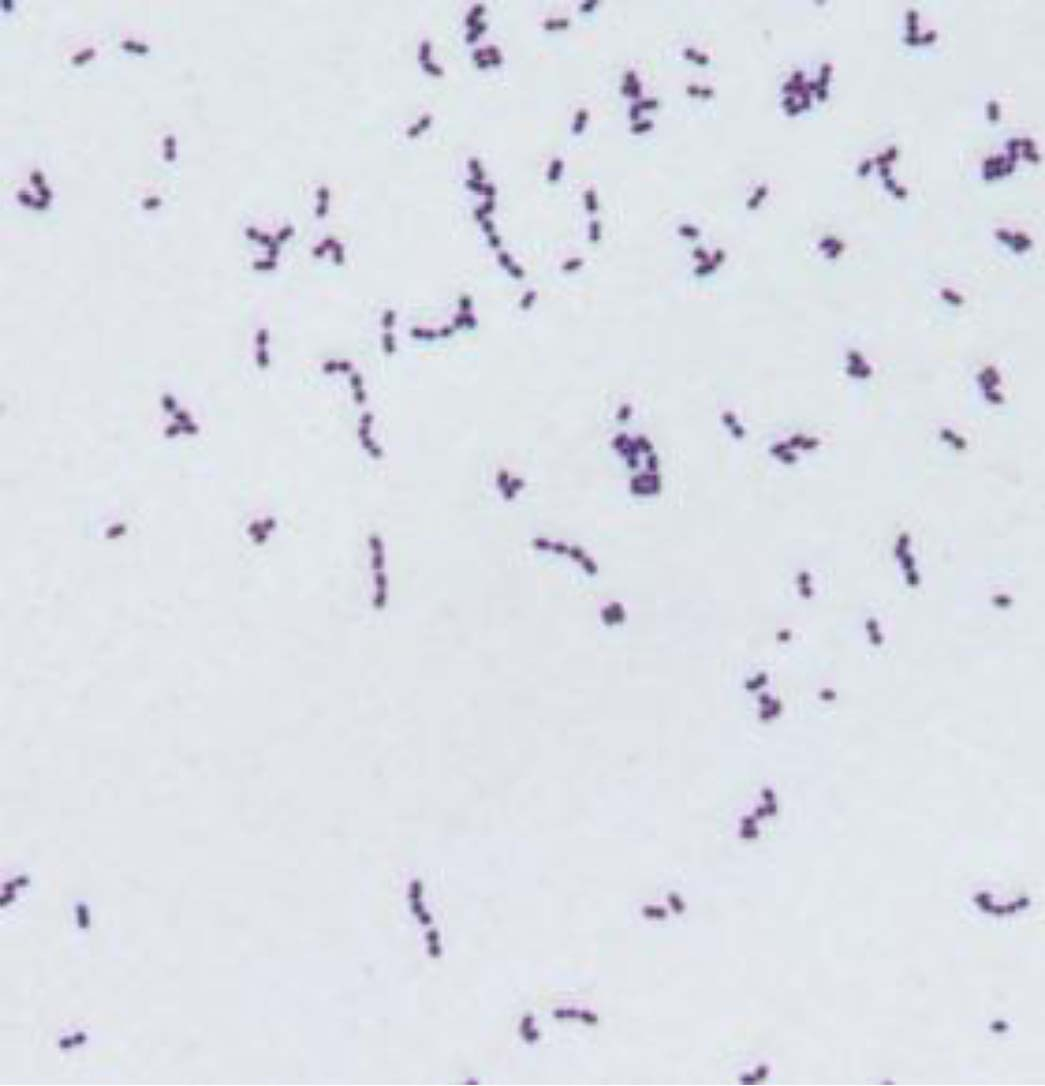
qw5.jpg

|
|
马上注册,结交更多好友,享用更多功能,让你轻松玩转社区。
您需要 登录 才可以下载或查看,没有账号?立即注册

x
Reynolds, D. L., Hille, M. M., & Jia, B. (2024). Review of Enterococcus faecalis Infections of Poultry. Avian Diseases , 68(S1): 412-420.

01摘要
粪肠球菌 ( Enterococcus faecalis ) 是一种革兰氏阳性球菌,广泛存在于水、土壤等环境中,也是脊椎动物和无脊椎动物肠道的共生菌群。虽然其通常被视为肠道微生物群的共生部分,但在特定条件下,它作为机会性病原体具有致病能力。本文综述了粪肠球菌在家禽中的感染情况,重点探讨了其分类学背景、致病机制、关键毒力因子(如生物膜形成、细胞溶素/溶血素产生)、垂直传播的证据(蛋传递)、以及在不同家禽品种(蛋鸡、肉鸡、火鸡)中引发的疾病表现,特别是淀粉样关节病。此外,本文还评估了目前用于检测粪肠球菌毒力特性的方法,包括多位点序列分型(MLST)和胚胎致死试验(ELA),并指出了基因型与表型之间相关性研究的不足。
02引言与分类学
1.1 分类学地位
粪肠球菌的生物学分类如下:- 门 (Phylum): 厚壁菌门 (Firmicutes)
- 纲 (Class): 芽孢杆菌纲 (Bacilli)
- 目 (Order): 乳杆菌目 (Lactobacillales)
- 科 (Family): 肠球菌科 (Enterococcaceae)
- 属 (Genus): 肠球菌属 ( Enterococcus )
- 种 (Species): 粪肠球菌 ( faecalis )
该细菌为革兰氏阳性、过氧化氢酶阴性的卵圆形球菌,通常以单个、成对或短链形式存在(见图 1)。历史上,粪肠球菌最初被归类为血清D组粪链球菌 ( Streptococcus faecalis ),后基于分子分析被重新归入肠球菌属。因此,在早期文献中,该菌常被称为链球菌。
图 1 : 粪肠球菌的革兰氏染色显微照片(放大倍数 1200x)。图中显示细菌呈现革兰氏阳性(紫色),形态为球状,排列成对或短链状。
1.2 起源与环境分布
基于化石记录和分子技术推测,肠球菌属起源于4.25亿至5亿年前,与动物的陆生化进程平行。该属名由Thiercelin在19世纪提出。粪肠球菌无处不在,存在于淡水、海水、土壤、植物及动物体内。在人类中,它是定植于肠道的最早细菌之一,尽管仅占肠道微生物群总量的不到1%。
1.3 临床重要性转变
虽然早期医学界认为肠球菌是无害的,但现在它已被确认为导致菌血症、尿路感染、心内膜炎及手术伤口感染的主要医院获得性病原体,且是多重耐药性的主要来源之一。
03致病机制与毒力因子
粪肠球菌的感染通常被推测为内源性的:细菌在胃肠道定植,通过肠上皮细胞易位,经淋巴系统进入血液循环扩散。导致肠道菌群失调的因素(如应激、抗生素使用、饮食改变)可能促使粪肠球菌过度生长并发生易位。
2.1 关键毒力因子
文献详细列举了与家禽疾病相关的毒力性状及其关联基因:
表 1:粪肠球菌毒力性状及相关基因

2.2 细胞溶素 (Cytolysin)
细胞溶素(常被称为溶血素)是一种独特的孔形成外毒素,对原核细胞和真核细胞均有活性。- 抑菌作用: 作为细菌素,它能抑制竞争性革兰氏阳性菌的生长,帮助粪肠球菌定植。
- 毒性作用: 对真核细胞具有毒性,导致组织损伤并增加致死率。
- 溶血特性: 其溶血能力因红细胞来源而异。粪肠球菌在马、人、狗、兔的红细胞上表现出溶血现象,但在 绵羊、牛或鹅 的红细胞上通常不溶血。作者特别指出, 鸡红细胞 对粪肠球菌的溶血作用不敏感,绵羊红细胞的敏感度也低于马红细胞。
2.3 生物膜与耐药性- 生物膜 (Biofilms): 通过菌毛交联形成,能在混合感染中促进形成。明胶酶在生物膜形成中起重要作用,并能降解胶原蛋白和明胶。
- 耐药性: 粪肠球菌对头孢菌素、氨基糖苷类等具有固有耐药性,并可通过信息素介导的接合质粒或转座子获得并传播耐药性。这引起了关于其作为人畜共患病原体潜在风险的关注。
04粪肠球菌作为家禽病原体
由于粪肠球菌在环境中无处不在且为机会性致病菌,确定其作为原发性病原体的角色具有挑战性。然而,多项研究表明其与特定疾病状况密切相关。
3.1 孵化场与早期生命阶段(垂直传播)
大量证据表明粪肠球菌存在垂直传播(母体至后代)。- 死胚与孵化率下降: 早在1993年及随后的2020年,Reynolds等人就报道了从死胚(特别是啄壳后未出壳的胚胎)中分离出粪肠球菌,导致野鸡种蛋孵化率从75%骤降至15%(见图 2)。
- 传播机制: 感染的胚胎或蛋一旦进入孵化器,会成为感染源。Fertner等人的研究表明,来自褐壳蛋亲本的雏鸡在出壳时感染率为14%,24小时后飙升至97%,证明了该菌在孵化过程中的快速传播能力。
- 蛋壳污染: 粪便污染蛋壳,细菌穿透进入。
- 经卵巢传播: 细菌经母鸡菌血症进入卵黄。
- 精液带菌 (Bacteriospermia): 雄性生殖道感染导致精液带菌,进而感染受精卵。

图 2: 未孵化的环颈雉鸡(ring-neck pheasant)种蛋。注意图片显示蛋壳已经被啄破(pipped),但胚胎未能完成出壳过程。从这些蛋的表面及胚胎的内脏器官中均分离出了粪肠球菌。
3.2 蛋鸡(淀粉样关节病)
淀粉样关节病 (Amyloid Arthropathy) 是粪肠球菌在蛋鸡中引起的最典型疾病。- 病变: 剖检可见肝脏呈青铜色,关节液呈橙色,组织学检查显示淀粉样变性。
- 诱发: Landman等人通过静脉注射高剂量粪肠球菌成功复制了该病,证明了特定菌株(淀粉样变性菌株)的致病性。气管内接种也能导致约30%的鸡发病,而肌肉注射发病率更高。
- 基因型关联: 某些序列类型(如 ST82, ST49)在患病鸡群中分布广泛,表明特定克隆株与该病相关。
3.3 肉鸡- 多发性关节炎与败血症: 粪肠球菌可引起肉鸡败血症和瓣膜性心内膜炎。
- 肺动脉高压: 静脉或腹腔注射高剂量粪肠球菌可导致肉鸡肺动脉高压。
- 脊椎骨髓炎: 虽然盲肠肠球菌 ( E. cecorum ) 是肉鸡脊椎骨髓炎的主要病因,但粪肠球菌也被证实能引起此病。
- 环境来源: 研究发现肉鸡垫料不利于粪肠球菌生存,因此垫料不太可能是主要的环境感染源。
3.4 火鸡- 肝肉芽肿: 早在1968年就有报告称粪肠球菌(当时称为粪链球菌)与火鸡肝肉芽肿有关,通常发生在肠道屏障受损时。
- 近期研究: 德国的一项研究从肉火鸡中分离出粪肠球菌,并未发现基因型与胚胎致死性表型之间存在明确相关性。
05评估粪肠球菌的方法
4.1 分离与鉴定- 培养: 常规使用血琼脂平板和CNA琼脂(选择性培养基)。
- MALDI-TOF MS(基质辅助激光解吸电离飞行时间质谱): 新兴技术,快速、准确,已被验证可用于野生鸟类和家禽来源的肠球菌鉴定(Stepien-Psyniak等,2017)。
4.2 毒力评估- 胚胎致死试验 (ELA): 长期以来用于评估细菌毒力。将细菌接种于鸡胚(通常经尿囊腔),观察死亡率。虽然Blanco等人建立了精确的LD50测定模型,但该方法资源消耗大,且不同研究间结果存在变异性。
- 基因分型: 如多位点序列分型 (MLST) 和 ERIC-PCR。
- 局限性: 尽管检测到了多种毒力基因,但基因型(存在毒力基因)与表型(实际致病力)之间的相关性尚未完全建立。许多携带毒力基因的分离株在ELA中并未表现出高致死率,这可能归因于基因的沉默或功能缺失。
06结论
粪肠球菌作为一种普遍存在的微生物,既是家禽肠道的共生菌,也是重要的机会性病原体。- 传播: 垂直传播(经蛋)已得到确证,孵化场内受感染的雏鸡可成为超级传播者,导致同群雏鸡快速感染。
- 疾病: 它是蛋鸡淀粉样关节病的主要病原,并与种蛋孵化率降低、胚胎死亡及肉鸡的败血症相关。
- 毒力: 具有多种毒力因子(生物膜、细胞溶素、耐药性),但目前尚无明确的生物标志物能绝对区分致病菌株与共生菌株。
- 挑战: 未来的研究需要进一步阐明毒力基因的表达调控,以及寻找更可靠的致病性预测指标。
07参考文献
- Devriese, L. A. , Hommez, J., Wijfels, R., & Haesebrouck, F. (1991). Composition of the enterococcal and streptococcal intestinal flora of poultry. Journal of Applied Bacteriology , 71, 46–50. (关于家禽肠道菌群组成的早期奠基性研究)
- Fertner, M. , Olsen, R., Bisgaard, M., & Christensen, H. (2011). Transmission and genetic diversity of Enterococcus faecalis among layer chickens during hatch. Acta Veterinaria Scandinavica , 53, 56. (证明孵化期间快速水平传播的关键研究)
- Landman, W. J. M. , Gruys, E., & Dwars, R. M. (1994). A syndrome-associated with growth depression and amyloid arthropathy in layers-a preliminary report. Avian Pathology , 23, 461–470. (首次报道蛋鸡淀粉样关节病)
- Landman, W. J. , Feberwee, A., Mekkes, D. R., Veldman, K. T., & Mevius, D. J. (1999). A study on the vertical transmission of arthropathic and amyloidogenic Enterococcus faecalis . Avian Pathology , 28, 559–566. (垂直传播的实验性证据)
- Maasjost, J. , Lüschow, D., Kleine, A., Hafez, H. M., Mühldorfer, K., & Bondi, M. (2019). Presence of virulence genes in Enterococcus species isolated from meat turkeys in Germany does not correlate with chicken embryo lethality. BioMed Research International , 2019, 6147695. (关于基因型与表型相关性缺失的讨论)
- Petersen, A. , Christensen, H., Philipp, H. C., & Bisgaard, M. (2009). Clonality of Enterococcus faecalis associated with amyloid arthropathy in chickens evaluated by multilocus sequence typing (MLST). Veterinary Microbiology , 134, 392–395. (关于淀粉样关节病相关菌株克隆性的研究)
- Reynolds, D. L. , & Loy, J. D. (2020). Decrease in hatchability of pheasant eggs associated with Enterococcus faecalis . Avian Diseases , 64, 517–521. (关于野鸡孵化率下降及死胚的研究)
- St?pień-Py?niak, D. , Hauschild, T., Dec, M., Marek, A., Urban-Chmiel, R., & Kosikowska, U. (2021). Phenotypic and genotypic characterization of Enterococcus spp. from yolk sac infections in broiler chicks with a focus on virulence factors. Poultry Science , 100, 100985. (关于卵黄囊感染及毒力因子的详细特征分析)
- Tankson, J. D. , Thaxton, J. P., & Vizzier-Thaxton, Y. (2001). Pulmonary hypertension syndrome in broilers caused by Enterococcus faecalis . Infection and Immunity , 69, 6318–6322. (关于肉鸡肺动脉高压的研究)
- Van Tyne, D. , Martin, M. J., & Gilmore, M. S. (2013). Structure, function, and biology of the Enterococcus faecalis cytolysin. Toxins , 5, 895–911. (关于关键毒力因子细胞溶素的详细综述)
来源:菌中无戏言,作者:凤凰于飞
|
|